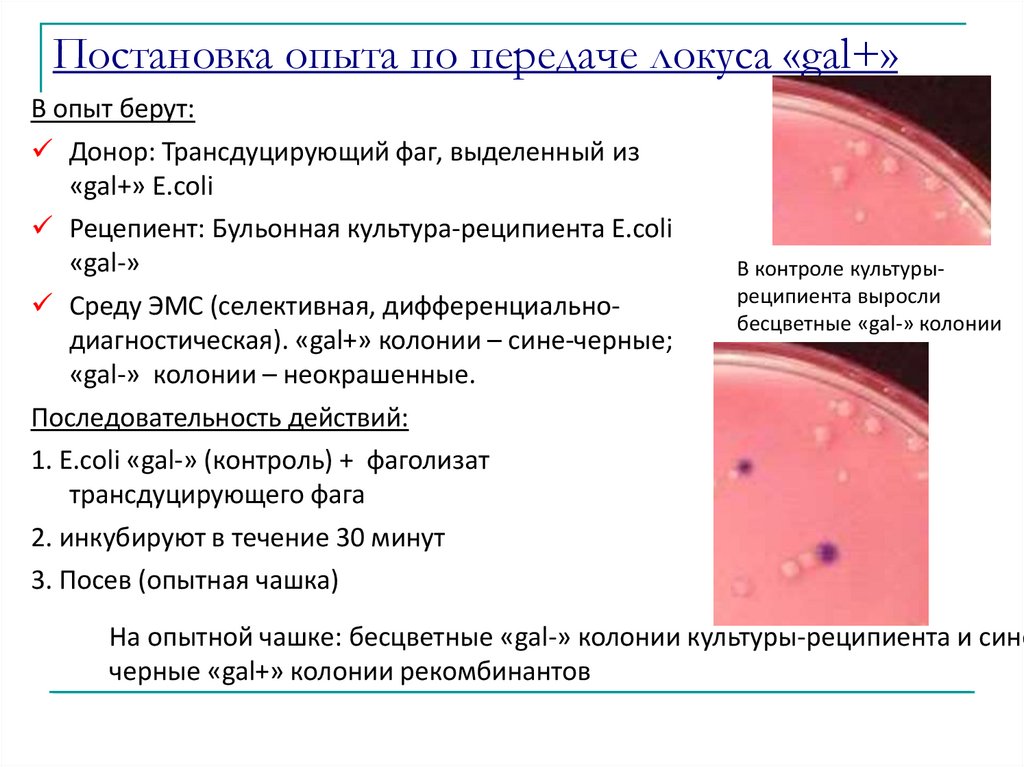

Similar presentations:
генетич рекомбинации (1)
1.
Генетическиерекомбинации у бактерий
Выполнила: Рябчун Александра
2.
В эволюции бактерий горизонтальный генетическийобмен играет ту же роль, что и половое размножение у
высших организмов
Адаптивная эволюция бактерий идет за счет
распространения отдельных генов, а не целых геномов, то
есть так же, как у организмов, размножающихся половым
путем.
Из этого следует, что в ходе адаптации к новым
условиям горизонтальный генетический обмен успешно
заменяет бактериям половое размножение.
3.
4.
Общие особенности для всех способов обмена генетическойинформацией у бактерий:
1.
Процесс переноса ДНК всегда односторонний, или
однонаправленный: от донорных бактерий к реципиентным.
1.
Полного обмена генетической информацией не наблюдается,
результатом чего является образование мерозиготы.
Состояние мерозиготы носит относительно
непродолжительный характер, в конечном итоге экзогенота
должна встроиться в эндогеноту. Если этого не происходит,
то экзогенота элиминируется эндонуклеазами клеткиреципиента.
5.
Общие особенности для всех способов обмена генетическойинформацией у бактерий (продолжение):
3. Для образования рекомбинантного (гибридного)
потомства процесс генетического переноса должен
обязательно закончиться рекомбинацией.
За рекомбинацией следует процесс репликации ДНК
и деление клетки. В результате чего возникают
клетки, содержащие только рекомбинантную
хромосому.
Такие клетки называются рекомбинантами.
4. Могут происходить как естественным путем, так и
при искусственных манипуляциях.
6.
Генетичекий обмен у бактерийпроцесс передачи генетического материала у бактерий
Основные пути осуществления:
-трансформация
-трансдукция
-конъюгация
Конечным этапом генетического обмена, который может быть
как внутривидовым, так и межвидовым, является
рекомбинация.
7.
Рекомбинацияпроцесс взаимодействия между молекулами ДНК,приводящей к
формированию новой рекомбинантной молекулы, несущей признаки от
бактерии-донора и от бактерии-реципиента.
8.
ТрансформацияТрансформация – механизм горизонтального переноса генов,
при котором участок нативной молекулы ДНК донора
захватывается бактерией-реципиентом и вызывает изменение ее
генома.
В отличие от других типов горизонтального переноса генов,
процесс трансформации полностью управляется клеткойрецепиентом и в него не вовлечены «эгоистичные» генетические
элементы.
В природных условиях геномная ДНК часто высвобождается при
гибели и лизисе бактериальных клеток
9.
Трансформацию описал Ф. Гриффит 1928 г. Установили О. Эвери, К.Мак-Леод, М. Мак-Карти 1944г.
Для эксперимента Ф.Р. Гриффит использовал два разных штамма
пневмококов:
Бескапсульный невирулентный штамм R (от англ.: rough –
шероховатый) растёт в виде шероховатых колоний.
Бактерии штамма R при введении в организм мышей не вызывают
гибели подопытных животных (рис., А).
Клетки другого – вирулентного штамма S (от англ.: smooth –
гладкий) имеют полисахаридную капсулу и образуют гладкие
колонии.
Мыши, после заражения этими бактериями, заболевают и гибнут
(рис., Б).
10.
Ф. Гриффит убивал клетки S-штамма нагреванием и смешивал их спневмококками из бескапсульного невирулентного R-штамма (В).
Смесь живых R- и мертвых S-клеток впрыскивал мышам.
Так как подопытные мыши не получили живых вирулентных
бактерий, можно было ожидать, что они выживут.
Однако подопытная партия мышей после опыта погибла (рис., Г).
Изучение популяций бактерий, размножавшихся в инфицированных
мышах, показало, что часть невирулентных клеток R-штамма
превратилась в вирулентные клетки S.
11.
Стадии трансформации1. Адсорбция фрагментов двунитевой
ДНК донора на сократимых пилях IV
типа. При их сокращении ДНК
протягивается через клеточную стенку
бактерий и приближается к
цитоплазматической мембране.
2. Транспортировка ДНК через
цитоплазматическую мембрану с
помощью специфического переносчика.
В ходе этого процесса одна цепь
подвергается расщеплению.
3. Проникший в цитоплазму
одноцепочечный фрагмент ДНК
рекомбинирует со схожим участком
генома клетки реципиента
(гомологичная рекомбинация).
12.
13.
14.
Условия, необходимые для успешнойтрансформации:
Гомологичность ДНК: ДНК донора должна быть
выделена из бактериальной культуры того же вида, что
и реципиент(или близкородственного)
Участок трансформирующей ДНК с молекулярным
весом 10-30 мегадальтон должен сохранять
двунитчатую суперспирализцию
Концентрация ДНК не должна быть малой или
избыточной, в обоих случаях количество
рекомбинантов снижается
Клетки-реципиенты должны быть компетентными, т.е.
обладать системой транспорта ДНК из внешней среды
в цитоплазму
15.
КомпетентностьКомпетентные клетки несут на поверхности фактор
компетентности.
Свою роль в развитие компетентности вносит плотность
бактериальной культуры, стадия роста культуры, недостаток
питательных веществ
Увеличить компетентность можно обработкой некоторыми
химическими агентами или воздействием сильным
электрическим полем (электропорация)
Электропорация — создание пор в бислойной липидной мембране под
действием электрического поля. Это явление используется в биотехнологии для
внедрения макромолекул (обычно ДНК или РНК)
в клетки млекопитающих, бактерий или растений.
16.
Постановка опыта по передаче локусаустойчивости к стрептомицину
Донор: ДНК
стрептомицинустойчивого штамма
Рецепиент:
стрептомицинчувствительная
культура в компетентном состоянии
Селективную среда, содержащую
стрептомицин
Последовательность действий:
1. Компетентные клетки реципиента соединяют с ДНК донора и инкубируют
2. В пробирку вносят ДНК-азу для разрушения не проникшей в реципиентные
клетки ДНК
3. Полученную смесь высевают на чашки с селективной средой и инкубируют.
4. Делают контрольные высевы ДНК донора и культуры-реципиента на
селективной среде (роста нет)
17.
Трансдукция(Н. Циндер и Дж. Ледерберг, 1951 г.)
процесс переноса генетического материала от
бактерии-донора к бактерии-реципиенту с
помощью бактериофага
специфическая
неспецифическая
(Умеренные фаги)
(Вирулентные фаги)
абортивная
18.
Неспецифическаятрансдукция:
За счёт ошибки при сборке
фаговой частицы в зараженной
клетке - в её головку вместо
генома бактериофага может быть
случайно включен любой участок
ДНК донора, имеющий
подходящий размер.
Образовавшийся дефектный
бактериофаг сохраняет
инфекционные свойства и
способен переносить включенную
ДНК в клетку-реципиент.
осуществляют вирулентные
фаги
19.
Основные этапы:1. Адсорбция
2. Репродукция
4. Гомологичная рекомбинация и включение
фрагмента перенесенной ДНК в геном
клетки-реципиента.
3.Перенос дефектным фагом
включенной ДНК в клетку-реципиент
20.
Специфическая трансдукцияфаг переносит определенные гены от бактериидонора к бактерии-реципиенту
Связан с интеграцией умеренного
фага в определенной участок
хромосомы клетки донора.
При вырезании профага из
хромосомы могут захватываться
соседние бактериальные гены.
При этом теряется фрагмент
собственной ДНК фага такого же
размера и
формируется дефектный
трансдуцирующий бактериофаг,
способный переносить захваченный
фрагмент ДНК донора и интегрировать
его в геном клетки-реципиента по
механизму сайт-специфической
рекомбинации (дополнение генома).
Основные исследования проводились на
системе Escherichia coli - бактериофаг λ
(«лямбда»), которая способна переносить
расположенные рядом опероны gal (кодирует
белки, обеспечивающие сбраживание
галактозы) или bio (кодирует ферменты
синтеза биотина).
21.
Специфическаятрансдукция
22.
Абортивная трансдукциятрансдукция, при которой перенесенный материалпередается только одной из двух дочерних клеток.
Как отмечалось выше, процесс
неспецифической трансдукции
завершается гомологичной
рекомбинацией и включением
фрагмента перенесенной ДНК
в клетку-реципиент.
Но при отсутствии гомологии
между ДНК донора и ДНК
реципиента рекомбинации не
происходит и привнесенный
фрагмент вскоре теряется
(абортивная трансдукция).
23.
Постановка опыта по передаче локуса «gal+»В опыт берут:
Донор: Трансдуцирующий фаг, выделенный из
«gal+» E.coli
Рецепиент: Бульонная культура-реципиента E.coli
«gal-»
Среду ЭМС (селективная, дифференциальнодиагностическая). «gal+» колонии – сине-черные;
«gal-» колонии – неокрашенные.
Последовательность действий:
1. E.coli «gal-» (контроль) + фаголизат
трансдуцирующего фага
2. инкубируют в течение 30 минут
3. Посев (опытная чашка)
В контроле культурыреципиента выросли
бесцветные «gal-» колонии
На опытной чашке: бесцветные «gal-» колонии культуры-реципиента и сине
черные «gal+» колонии рекомбинантов
24.
Конъюгация- форма обмена генетическим материалом между
бактериями при их непосредственном
клеточном контакте.
Процесс конъюгации у бактерий впервые был обнаружен
Джошуа Ледербергом и Эдвардом Тейтумом в 1946 г.
25.
Адсорбция фагов на бактериальной клетке26.
27.
Морфологические типыфагов.
I – нитевидные фаги
II – фаги без отростка
III- фаги с аналогом отростка
IV – фаги с коротким
отростком
V – фаги с длинным
несокращающимся отростком
VI– фаги с длинным
сокращающимся отростком
28.
F-фактор29.
30.
Типы скрещивания:1. Скрещивание F+ x F- :передается только F-плазмида, при
этом F- клетка становится F+-клеткой,приобретая
плазмиду и свойства донора. Хромосомные гены не
передаются.
F + x F-
2F+
31.
32.
Этапы конъюгации F+ x F1. F+ клетка с помощью F-пилиприкрепляется к поверхности Fклетки.
При сокращении F-пили клетки
подтягиваются друг к другу.
При этом канал, проходящий
внутри F-пили, формирует
конъюгационный мостик,
соединяющий цитоплазмы двух
клеток
.
33.
2. В F+ клетке ферментрелаксаза делает
обратимый
одноцепочечный разрыв в
кольцевой молекуле Fплазмиды в точке начала
переноса, прикрепляясь к
образовавшемуся 5’-концу
цепи ДНК.
34.
3. Молекула релаксазытранспортируется через
конъюгационный мостик из F+
клетки в F-, протягивая через него
одну цепь F-плазмиды. Этот процесс
сопровождается достройкой второй
цепи ДНК как в донорной, так и в
реципиентной клетке.
4. Конъюгационный мостик
разрушается, двухцепочечная
кольцевая структура F-плазмиды
восстанавливается в обоих клетках.
35.
Типы скрещивания:2. Скрещивание Hfr x F-
36.
2. Скрещивание Hfr x F1. Белок (кодируемый tra – опероном) узнаетопределенную последовательность в ДНК
плазмиды (origin), затем разрывает одну цепь ДНК и
связывается с 5ʹ -концом.
2. Цепь ДНК с которой связан белок, переносится в
клетку, двигаясь 5'-концом вперёд – реципиент, а
другая остаётся в Hfr-клетке, то есть донор
сохраняет своё генетическое постоянство.
3 После начала конъюгации хромосомный материал
переносится, начиная от генов, близких к начальной
точке транспорта.
Для полного проникновения всей хромосомной
нити Escherichia coli требуется 90 минут и
последним переходит оставшийся участок
интегрированной F-плазмиды.
Полный переход осуществляется редко.
Как правило, непрочный конъюгационный мостик
рвется гораздо раньше и в клетку-реципиент
проникает только фрагмент ДНК бактериальной
клетки большей или меньшей длины.
37.
Скрещивание F’ x F- : (есть рекомбинанты)происходит аналогично скрещиванию F+ x F- и
реципиентная клетка превращается в донорную
38.
Постановка опыта скрещивания Hfr x F- по передачелокусов Pro, Thr, Leu
В опыт берут:
Донор-штамм с генотипом Hfr Pro +, Thr+, Leu+ , чувствительный к
стрептомицину
Реципиент-штамм с генотипом F- Pro-, Thr-, Leu- , резистентный к
стрептомицину
Минимальный агар, содержащий стрептомицин
Последовательность действий:
1. В опытную пробирку вносят культуры донора и реципиента,
инкубируют в течение 30 минут
2. Готовят разведения и высевают на селективную среду, инкубируют
3. Делают контрольные высевы культуры донорных и реципиентных
клеток на чашки с селективной средой
Результаты опыта:
1. На контрольных чашках рост отсутствует (донор не может расти из-за
чувствительности к антибиотику, рецепиент – ауксотроф)
2. На опытной чашке вырастают рекомбинанты – прототрофы,
устойчивые к стрептомицину

biology
biology








